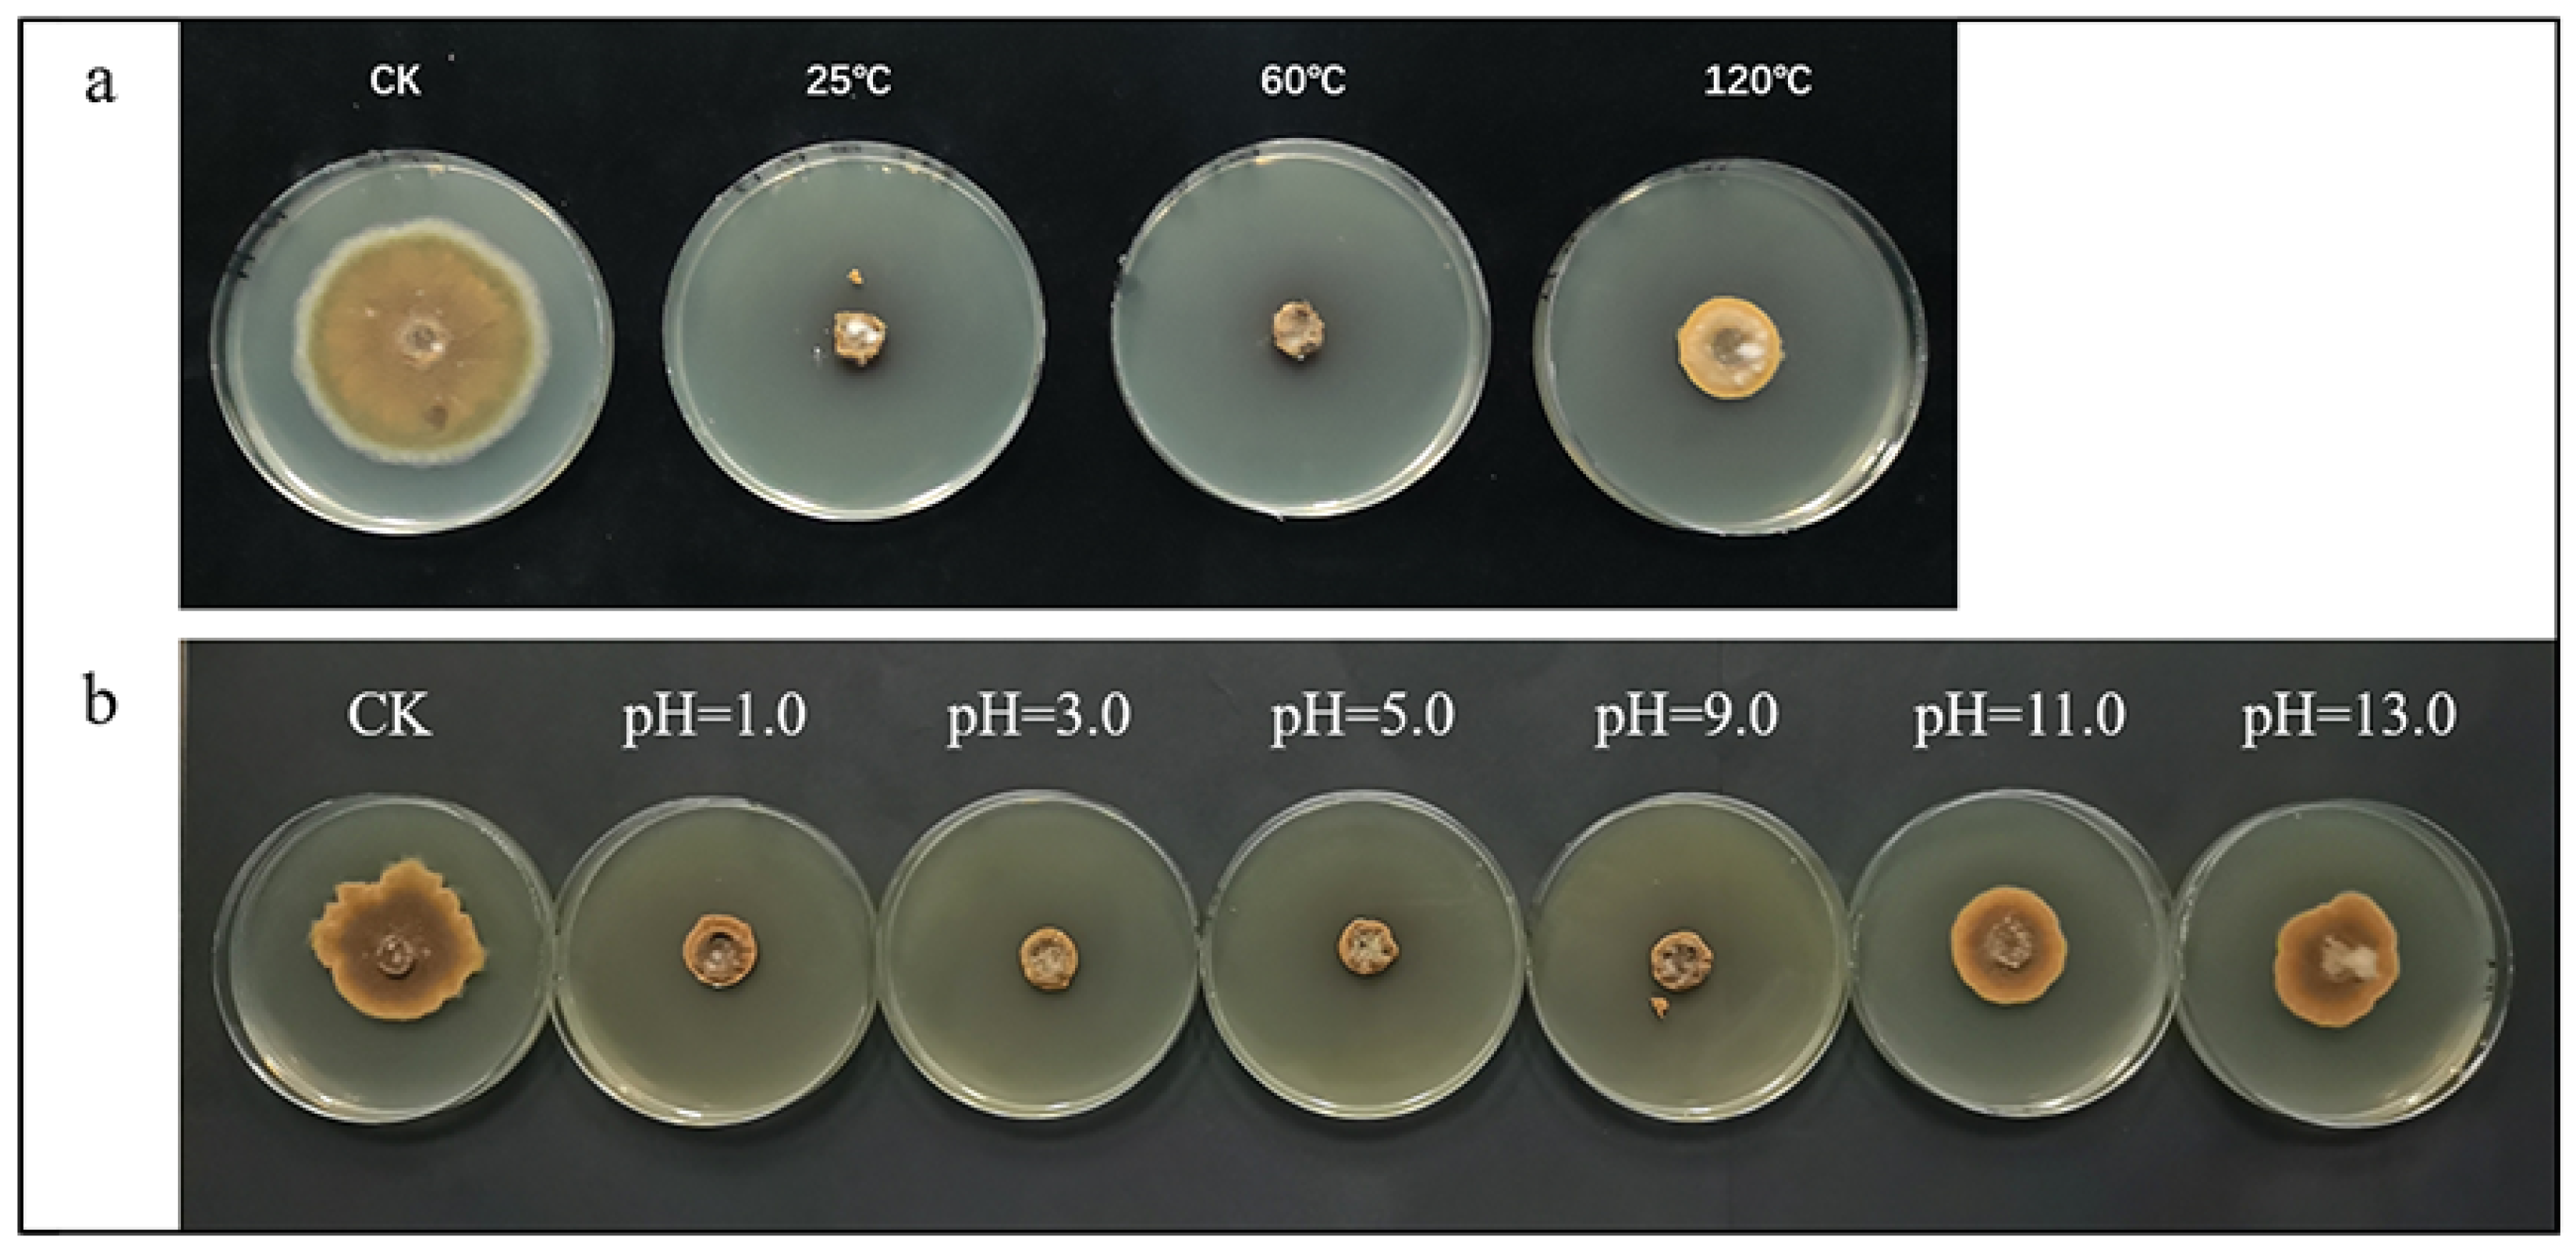
Toxins 16 00065 g002

Crude Lipopeptides Produced by Bacillus amyloliquefaciens Could Control the Growth of Alternaria alternata and Production of Alternaria Toxins in Processing Tomato
Abstract
1. Introduction
2. Results and Discussion
2.1. Effect of Crude Lipopeptides Treatment on Mycelial Growth of A. alternata
2.2. Stability Test of Anti-Fungal Activity of Crude Lipopeptides
2.3. Inhibition Mechanism of Crude Lipopeptides on A. alternata
2.3.1. Observation of Mycelium and Spores Microstructure
2.3.2. Effect of Crude Lipopeptides Treatment on the Membrane Integrity of A. alternata Spore Cells
2.3.3. Effect of Crude Lipopeptides Treatment on Conductivity of A. alternata Mycelium
2.4. Effect of Crude Lipopeptides on the Content of Alternaria Toxins
2.5. Effect of Crude Lipopeptides on A. alternata and Its Toxins on Tomato
2.6. Effect of Crude Lipopeptides on the Expression of Key Genes Related to Alternaria Toxins
2.7. Discussion of the Possible Inventory Path to Alternaria Toxins
3. Conclusions
4. Materials and Methods
4.1. Microorganisms and Culture Conditions
4.2. Chemicals and Reagents
4.3. Instruments
4.4. Experimental Methods
4.4.1. Extraction of Crude Lipopeptides
4.4.2. Effect of Crude Lipopeptides on the Growth of A. alternata
4.4.3. Stability Experiments of Crude Lipopeptides
4.4.4. Effect of Crude Lipopeptides on the Mycelium and Spores of A. alternata
4.4.5. Effects of Crude Lipopeptides on Cell Membrane Integrity of A. alternata
4.4.6. Determination of Mycelial Conductivity
4.4.7. Effect of Crude Lipopeptides on the Content of Alternaria Toxins
4.4.8. Effect of Crude Lipopeptides on A. alternata and Toxins in Tomatoes
4.4.9. Detection of Alternaria Toxins Using UPLC-MS/MS
4.4.10. Real-Time Quantitative Polymerase Chain Reaction Analysis (qRT-PCR)
4.5. Statistical Analysis
Author Contributions
Funding
Institutional Review Board Statement
Informed Consent Statement
Data Availability Statement
Conflicts of Interest
References
- Viuda-Martos, M.; Sanchez-Zapata, E.; Sayas-Barberá, E.; Sendra, E.; Pérez-Alvarez, J.A.; Fernández-López, J. Tomato and Tomato Byproducts. Human Health Benefits of Lycopene and Its Application to Meat Products: A Review. Crit. Rev. Food Sci. Nutr. 2014, 54, 1032–1049. [Google Scholar] [CrossRef]
- Dong, X.X.; Zhang, Z.Y.; Wang, S.M.; Shen, Z.H.; Cheng, X.J.; Lv, X.H.; Pu, X.Z. Soil properties, root morphology and physiological responses to cotton stalk biochar addition in two continuous cropping cotton field soils from Xinjiang, China. PeerJ 2022, 10, e12928. [Google Scholar] [CrossRef]
- Veroustraete, F.; Li, Q.; Verstraeten, W.W.; Chen, X.; Bao, A.M.; Dong, Q.H.; Liu, T.; Willems, P. Soil moisture content retrieval based on apparent thermal inertia for Xinjiang province in China. Int. J. Remote Sens. 2012, 33, 3870–3885. [Google Scholar] [CrossRef]
- Atlas Big. World Tomato Production by Country. Available online: https://www.atlasbig.com/en-gb/countries-by-tomato-production#google_vignette (accessed on 18 January 2024).
- Li, L.Y.; Bai, J.; Wu, Z.H.; Halihash, Y.; Li, Q.J. Effects of N, P and K Application Time on Yield, Quality and Nutrient Uptake of Processing Tomato Under Chemical Fertilizer Reduction. Chin. Agric. Sci. Bull. 2023, 39, 58–63. [Google Scholar] [CrossRef]
- Liu, W.J.; He, X.Y.; Fu, J.W.; Wu, J.H. Identification and toxigenic analysis of Alternaria sp. in tomato. J. Food Saf. Qual. 2021, 12, 8517–8522. [Google Scholar]
- Graf, E.; Schmidt-Heydt, M.; Geisen, R. HOG MAP kinase regulation of alternariol biosynthesis in Alternaria alternata is important for substrate colonization. Int. J. Food Microbiol. 2012, 157, 353–359. [Google Scholar] [CrossRef] [PubMed]
- Wenderoth, M.; Garganese, F.; Schmidt-Heydt, M.; Soukup, S.T.; Ippolito, A.; Sanzani, S.M.; Fischer, R. Alternariol as virulence and colonization factor of Alternaria alternata during plant infection. Mol. Microbiol. 2019, 112, 131–146. [Google Scholar] [CrossRef] [PubMed]
- Yun, C.S.; Motoyama, T.; Osada, H. Regulatory Mechanism of Mycotoxin Tenuazonic Acid Production in Pyricularia oryzae. ACS Chem. Biol. 2017, 12, 2270–2274. [Google Scholar] [CrossRef] [PubMed]
- Sun, F.; Cao, X.Q.; Yu, D.Z.; Hu, D.Q.; Yan, Z.; Fan, Y.Y.; Wang, C.; Wu, A.B. AaTAS1 and AaMFS1 Genes for Biosynthesis or Efflux Transport of Tenuazonic Acid and Pathogenicity of Alternaria alternata. Mol. Plant-Microbe Interact. 2022, 35, 416–427. [Google Scholar] [CrossRef]
- Meena, M.; Gupta, S.K.; Swapnil, P.; Zehra, A.; Dubey, M.K.; Upadhyay, R.S. Alternaria Toxins: Potential Virulence Factors and Genes Related to Pathogenesis. Front. Microbiol. 2017, 8, 1451. [Google Scholar] [CrossRef]
- Liu, G.T.; Miao, J.; Zhen, Y.Z.; Xu, Y.M.; Pei, L.C.; Zhang, P.; Zheng, Q.L.; Lou, Z.L.; Qian, Y.Z.; Ma, G.J. Etiological role of Alternaria alternata in human esophageal cancer. Chin. Med. J. 1992, 105, 394–400. [Google Scholar]
- Man, Y.; Liang, G.; Li, A.; Wang, D.; Jia, W.S.; Pan, L.G. Research progress of detecting methods for Alternaria toxins. J. Food Saf. Qual. 2016, 7, 453–458. [Google Scholar]
- Steyn, P.S.; Rabie, C.J. Characterization of Magnesium and Calcium Tenuazonate from Phoma sorghina. Phytochemistry 1976, 15, 1977–1979. [Google Scholar] [CrossRef]
- Zhou, B.; Qiang, S. Degradation of Tenuazonic Acid from Alternaria alternata in Soil. J. Agro-Environ. Sci. 2007, 26, 572–576. [Google Scholar]
- Lin, H.K.; Jia, B.X.; Wu, A.B. Cytotoxicities of Co-occurring alternariol, alternariol monomethyl ether and tenuazonic acid on human gastric epithelial cells. Food Chem. Toxicol. 2023, 171, 113524. [Google Scholar] [CrossRef]
- Zhang, S.W.; Wang, Y.; Chen, X.; Cui, B.J.; Bai, Z.H.; Zhuang, G.Q. Variety features differentiate microbiota in the grape leaves. J. Can. Microbiol. 2020, 66, 653–663. [Google Scholar] [CrossRef]
- Gajbhiye, M.; Kapadnis, B. Bio-efficiency of anti-fungal Lactic Acid Bacterial Isolates for Pomegranate Fruit Rot Management. Proc. Natl. Acad. Sci. India Sect. B Biol. Sci. 2018, 88, 1477–1488. [Google Scholar] [CrossRef]
- Shi, X.J.; Zeng, K.X.; Wang, X.Y.; Liang, Z.H.; Wu, X.H. Characterization of Alternaria species causing leaf spot on Chinese cabbage in Shanxi province of China. J. Plant Pathol. 2021, 103, 283–293. [Google Scholar] [CrossRef]
- Jiang, D.M.; Wei, D.Z.; Li, H.T.; Wang, L.Q.; Jiang, N.; Li, Y.C.; Wang, M. Natural occurrence of Alternaria mycotoxins in wheat and potential of reducing associated risks using magnolol. J. Sci. Food Agric. 2021, 101, 3071–3077. [Google Scholar] [CrossRef] [PubMed]
- Bathoova, M.; Svubová, R.; Bokor, B.; Nedela, V.; Tihlaríková, E.; Martinka, M. Silicon triggers sorghum root enzyme activities and inhibits the root cell colonization by Alternaria alternata. Planta 2021, 253, 29. [Google Scholar] [CrossRef] [PubMed]
- Estiarte, N.; Crespo-Sempere, A.; Marín, S.; Sanchis, V.; Ramos, A.J. Occurrence of Alternaria mycotoxins and quantification of viable Alternaria spp. during the food processing of tomato products in Spain. World Mycotoxin J. 2018, 11, 625–633. [Google Scholar] [CrossRef]
- Sanzani, S.M.; Gallone, T.; Garganese, F.; Caruso, A.G.; Amenduni, M.; Ippolito, A. Contamination of fresh and dried tomato by Alternaria toxins in southern Italy. Food Addit. Contam. Part A Chem. Anal. Control Expo. Risk Assess. 2019, 36, 789–799. [Google Scholar] [CrossRef]
- Jürg, N.; Patrick, S.; Martin, R.; Hansruedi, S. Determination of six Alternaria toxins with UPLC-MS/MS and their occurrence in tomatoes and tomato products from the Swiss market. Mycotoxin Res. 2011, 27, 265–271. [Google Scholar]
- Zhao, K.; Shao, B.; Yang, D.J.; Li, F.Q. Natural Occurrence of Four Alternaria Mycotoxins in Tomato- and Citrus-Based Foods in China. J. Agric. Food Chem. 2015, 63, 343–348. [Google Scholar] [CrossRef]
- Meena, K.R.; Kanwar, S.S. Lipopeptides as the anti-fungal and antibacterial agents: Applications in food safety and therapeutics. BioMed Res. Int. 2015, 2015, 473050. [Google Scholar] [CrossRef] [PubMed]
- Cozzolino, M.E.; Distel, J.S.; García, P.A.; Mascotti, M.L.; Ayub, M.J.; Benazzi, L.M.; Di Masi, S.N.; Silva, P.G. Control of postharvest fungal pathogens in pome fruits by lipopeptides from a Bacillus sp. isolate SL-6. Sci. Hortic. 2019, 261, 108957. [Google Scholar] [CrossRef]
- Chen, X.Y.; Zhang, Y.Y.; Fu, X.C.; Li, Y.; Wang, Q. Isolation and characterization of Bacillus amyloliquefaciens PG12 for the biological control of apple ring rot. Postharvest Biol. Technol. 2016, 115, 113–121. [Google Scholar] [CrossRef]
- Liao, J.H.; Chen, P.Y.; Yang, Y.L.; Kan, S.C.; Hsieh, F.C.; Liu, Y.C. Clarification of the Antagonistic Effect of the Lipopeptides Produced by Bacillus amyloliquefaciens BPD1 against Pyricularia oryzae via In Situ MALDI-TOF IMS Analysis. Molecules 2016, 21, 1670. [Google Scholar] [CrossRef]
- Jia, Q.L.; Fan, Y.Y.; Duan, S.S.; Qin, Q.M.; Ding, Y.; Yang, M.; Wang, Y.; Liu, F.J.; Wang, C. Effects of Bacillus amyloliquefaciens XJ-BV2007 on Growth of Alternaria alternata and Production of Tenuazonic Acid. Toxins 2023, 15, 53. [Google Scholar] [CrossRef] [PubMed]
- Shafi, J.; Tian, H.; Ji, M.S. Bacillus species as versatile weapons for plant pathogens: A review. Biotechnol. Biotec. Eq. 2017, 31, 446–459. [Google Scholar] [CrossRef]
- Jin, H.; Pfeffer, P.E.; Douds, D.D.; Piotrowski, E.; Lammers, P.J.; Shachar-Hill, Y. The uptake, metabolism, transport and transfer of nitrogen in an arbuscular mycorrhizal symbiosis. New Phytol. 2005, 168, 687–696. [Google Scholar] [CrossRef] [PubMed]
- Zhang, S.W.; Zheng, Q.; Xu, B.L.; Liu, J. Identification of the Fungal Pathogens of Postharvest Disease on Peach Fruits and the Control Mechanisms of Bacillus subtilis JK-14. Toxins 2019, 11, 322. [Google Scholar] [CrossRef] [PubMed]
- Zhang, S.M.; Wang, Y.X.; Meng, L.Q.; Li, J.; Zhao, X.Y.; Cao, X.; Chen, X.L.; Wang, A.X.; Li, J.F. Isolation and characterization of anti-fungal lipopeptides produced by endophytic Bacillus amyloliquefaciens TF28. Afr. J. Microbiol. Res. 2012, 6, 1747–1755. [Google Scholar]
- Shang, L.L.; Bai, X.X.; Chen, C.; Liu, L.J.; Li, M.Y.; Xia, X.S.; Wang, Y. Isolation and identification of a Bacillus megaterium strain with ochratoxin A removal ability and anti-fungal activity. Food Control 2019, 106, 106743. [Google Scholar] [CrossRef]
- Zhou, G.X.; Chen, Y.N.; Yao, J.Q. Variations in precipitation and temperature in Xinjiang (Northwest China) and their connection to atmospheric circulation. Front. Environ. Sci. J. 2023, 10, 1082713. [Google Scholar] [CrossRef]
- University of New Hampshire. Available online: https://extension.unh.edu/resource/growing-vegetables-tomatoes-fact-sheet-1#:~:text=Tomato%20plants%20will%20grow%20well,foliage%20but%20little%20fruit%20production (accessed on 18 January 2024).
- Wang, J.L.; Yang, J.K.; Feng, Z.G.; Liu, X.J.; Huang, J.Y.; Sun, H.G. Isolation and Stability Analysis of Lipopeptides Compound Produced by Bacillus subtilis Strain SYL-6. Modern. Agric. Sci. Technol. 2015, 44, 114–117. [Google Scholar]
- Wang, L.Q.; Wang, D.; Yuan, S.Z.; Feng, X.Y.; Wang, M. Transcriptomic Insights into the anti-fungal Effects of Magnolol on the Growth and Mycotoxin Production of Alternaria alternata. Toxins 2020, 12, 665. [Google Scholar] [CrossRef]
- Johnson, M.B.; Criss, A.K. Fluorescence Microscopy Methods for Determining the Viability of Bacteria in Association with Mammalian Cells. J. Vis. Exp. 2013, 79, e50729. [Google Scholar]
- Kaur, P.K.; Joshi, N.; Singh, I.P.; Saini, H.S. Identification of Cyclic lipopeptides produced by Bacillus vallismortis R2 and their anti-fungal activity against Alternaria alternata. J. Appl. Microbiol. 2017, 122, 139–152. [Google Scholar] [CrossRef]
- Casares, D.; Escribá, P.V.; Rosselló, C.A. Membrane Lipid Composition: Effect on Membrane and Organelle Structure, Function and Compartmentalization and Therapeutic Avenues. Int. J. Mol Sci. 2019, 20, 2167. [Google Scholar] [CrossRef]
- Rong, S.H.; Xu, H.; Li, L.H.; Chen, R.J.; Gao, X.L.; Xu, Z.J. anti-fungal activity of endophytic Bacillus safensis B21 and its potential application as a biopesticide to control rice blast. Pestic. Biochem. Physiol. 2020, 162, 69–77. [Google Scholar] [CrossRef]
- Zhang, X.; Li, B.; Wang, Y.; Guo, Q.; Lu, X.; Li, S.; Ma, P. Lipopeptides, a novel protein, and volatile compounds contribute to the anti-fungal activity of the biocontrol agent Bacillus atrophaeus CAB-1. Appl. Microbiol. Biotechnol. 2013, 97, 9525–9534. [Google Scholar] [CrossRef]
- Arrebola, E.; Sivakumar, D.; Bacigalupo, R.; Korsten, L. Combined application of antagonist Bacillus amyloliquefaciens and essential oils for the control of peach postharvest diseases. Crop Prot. 2010, 29, 369–377. [Google Scholar] [CrossRef]
- Zouari, I.; Jlaiel, L.; Tounsi, S.; Trigui, M. Biocontrol activity of the endophytic Bacillus amyloliquefaciens strain CEIZ-11 against Pythium aphanidermatum and purification of its bioactive compounds. Biol. Control 2016, 100, 54–62. [Google Scholar] [CrossRef]
- Hu, D.Q.; Yu, S.; Yu, D.Z.; Liu, N.; Tang, Y.; Fan, Y.Y.; Wang, C.; Wu, A.B. Biogenic Trichoderma harzianum-derived selenium nanoparticles with control functionalities originating from diverse recognition metabolites against phytopathogens and mycotoxins. Food Control 2019, 106, 106748. [Google Scholar] [CrossRef]
- Wu, J.J.; Chou, H.P.; Huang, J.W.; Deng, W.L. Genomic and biochemical characterization of anti-fungal compounds produced by Bacillus subtilis PMB102 against Alternaria brassicicola. Microbiol. Res. 2021, 251, 126815. [Google Scholar] [CrossRef]
- Yánez-Mendizábal, V.; Falconí, C.E. Bacillus subtilis CtpxS2-1 induces systemic resistance against anthracnose in Andean lupin by lipopeptide production. Biotechnol. Lett. 2021, 43, 719–728. [Google Scholar] [CrossRef]
- Xiong, K.; Zhi, H.W.; Liu, J.Y.; Wang, X.Y.; Zhao, Z.Y.; Pei, P.G.; Deng, L.; Xiong, S.Y. Detoxification of Ochratoxin A by a novel Aspergillus oryzae strain and optimization of its biodegradation. Rev. Argent. Microbiol. 2021, 53, 48–58. [Google Scholar] [CrossRef]
- Liu, Z.T.; Dong, Y.P.; Li, Y.C.; Bi, Y.; Li, B.J.; Jing, C.Y. anti-fungal Effect of ε-Polylysine on Alternaria alternata Isolated from Pears with Black Spot and Its Possible Mechanism. Food Sci. 2021, 42, 213–220. [Google Scholar]
- Kim, P.I.; Bai, H.; Bai, D.; Chae, H.; Chung, S.; Kim, Y.; Park, R.; Chi, Y.T. Purification and characterization of a lipopeptide produced by Bacillus thuringiensis CMB26. J. Appl. Microbiol. 2004, 97, 942–949. [Google Scholar] [CrossRef]
- Liu, J.L.; Xue, Y.R.; Liu, C.H. Optimization of shake flask-fermentation conditions for Iturin A production by endophytic Bacillus amyloliquefaciens CC09. Microbiol. Chin. 2014, 41, 75–82. [Google Scholar]
- Wang, C.; Fan, Y.Y.; He, W.Z.; Hu, D.Q.; Wu, A.B.; Wu, W.L. Development and Application of a QuEChERS-Based Liquid Chromatography Tandem Mass Spectrometry Method to Quantitate Multi-Component Alternaria Toxins in Jujube. Toxins 2018, 10, 382. [Google Scholar] [CrossRef] [PubMed]
- Estiarte, N.; Crespo-Sempere, A.; Marín, S.; Sanchis, V.; Ramos, A.J. Effect of 1-methylcyclopropene on the development of black mold disease and its potential effect on alternariol and alternariolmonomethyl ether biosynthesis on tomatoes infected with Alternaria alternata. Int. J. Food Microbiol. 2016, 236, 74–82. [Google Scholar] [CrossRef] [PubMed]
- Qin, Q.M.; Fan, Y.Y.; Jia, Q.L.; Duan, S.S.; Liu, F.J.; Jia, B.X.; Wang, G.Q.; Guo, W.H.; Wang, C. The Potential of Alternaria Toxins Production by A. alternata in Processing Tomatoes. Toxins 2022, 14, 827. [Google Scholar] [CrossRef]

| Analyte | Precursor Ion (m/z) | Product Ions (m/z) | Retention Time (min) | Collision Energy (eV) | Cone Voltage (V) |
|---|---|---|---|---|---|
| TeA | 196.1 | 138.9 * | 1.80 | 18 | 30 |
| 196.0 | 15 | ||||
| AOH | 257.0 | 213.2 * | 3.98 | 16 | 43 |
| 147.1 | 14 | ||||
| AME | 271.1 | 256.1 * | 5.42 | 17 | 46 |
| 228.2 | 15 | ||||
| TEN | 413.1 | 141.2 * | 5.00 | 19 | 30 |
| 214.2 | 13 |
| No. | Gene Name | Sequences (5′→3′) | References | |
|---|---|---|---|---|
| 1 | AaActin | F′ | GCAGCATGTACCCAGGTCTT | [9] |
| R′ | GGATCTTCGATGCGGACCTT | |||
| 2 | omtI | F′ | CAAGATCCCAAAGTCAAAGGA TGGTGGCCTACACTCTAATGG | [10,37] |
| R′ | GACGTCATATAATCATACGGC TAAGCCAGTGTTGCACCAATG | |||
| 3 | aohR | F′ | TCCTTATCCTGGACGACAT | [37] |
| R′ | GAGGTTGATGACGGCTTC | |||
| 4 | AaMFS1 | F′ | CCCCGGTGCTGTTGATGTGGATAG | [9] |
| R′ | TCGGACGCAATGGAGAGGAAGAGC | |||
| 5 | AaTAS1 | F′ | GGTCGAGCAGTCAAACCTGA | [9] |
| R′ | GTCGATGACAGTCGCGAGAT |
Disclaimer/Publisher’s Note: The statements, opinions and data contained in all publications are solely those of the individual author(s) and contributor(s) and not of MDPI and/or the editor(s). MDPI and/or the editor(s) disclaim responsibility for any injury to people or property resulting from any ideas, methods, instructions or products referred to in the content. |
© 2024 by the authors. Licensee MDPI, Basel, Switzerland. This article is an open access article distributed under the terms and conditions of the Creative Commons Attribution (CC BY) license (https://creativecommons.org/licenses/by/4.0/).
Share and Cite
Zhang, Y.; Fan, Y.; Dai, Y.; Jia, Q.; Guo, Y.; Wang, P.; Shen, T.; Wang, Y.; Liu, F.; Guo, W.; et al. Crude Lipopeptides Produced by Bacillus amyloliquefaciens Could Control the Growth of Alternaria alternata and Production of Alternaria Toxins in Processing Tomato. Toxins 2024, 16, 65. https://doi.org/10.3390/toxins16020065
Zhang Y, Fan Y, Dai Y, Jia Q, Guo Y, Wang P, Shen T, Wang Y, Liu F, Guo W, et al. Crude Lipopeptides Produced by Bacillus amyloliquefaciens Could Control the Growth of Alternaria alternata and Production of Alternaria Toxins in Processing Tomato. Toxins. 2024; 16(2):65. https://doi.org/10.3390/toxins16020065
Chicago/Turabian StyleZhang, Yuanyuan, Yingying Fan, Yingying Dai, Qinlan Jia, Ying Guo, Peicheng Wang, Tingting Shen, Yan Wang, Fengjuan Liu, Wanhui Guo, and et al. 2024. "Crude Lipopeptides Produced by Bacillus amyloliquefaciens Could Control the Growth of Alternaria alternata and Production of Alternaria Toxins in Processing Tomato" Toxins 16, no. 2: 65. https://doi.org/10.3390/toxins16020065
APA StyleZhang, Y., Fan, Y., Dai, Y., Jia, Q., Guo, Y., Wang, P., Shen, T., Wang, Y., Liu, F., Guo, W., Wu, A., Jiao, Z., & Wang, C. (2024). Crude Lipopeptides Produced by Bacillus amyloliquefaciens Could Control the Growth of Alternaria alternata and Production of Alternaria Toxins in Processing Tomato. Toxins, 16(2), 65. https://doi.org/10.3390/toxins16020065

